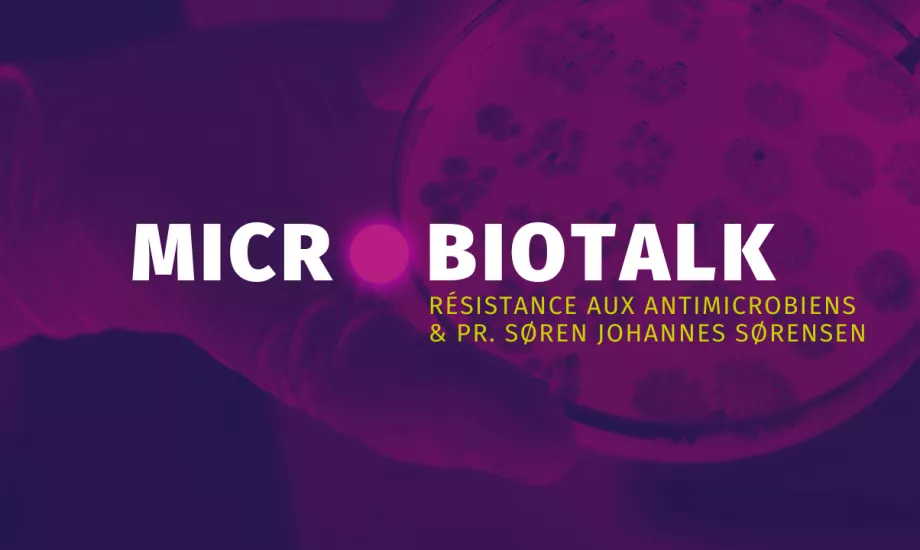
Vidéo du Pr Søren Johannes Sørensen sur la résistance aux antibiotiques et le microbiote intestinal du nourrisson.

Microbiotalk : conférences sur la résistance antimicrobienne
Connaissez-vous les MicrobioTalk ? Ce nouveau cycle de conférences imaginé par l'Institut des Microbiotes poursuit une ambition : partager et diffuser le plus massivement possible les dernières connaissances sur les microbiotes humains !
Alternant les présentations courtes et les discussions, les MicrobioTalks réunissent des experts du monde entier qui viennent présenter leurs travaux de recherche, les dernières avancées scientifiques liées aux microbiotes ou partager un retour d'expérience. Chercheurs, professionnels de santé, mais aussi patients, représentants d’associations de patients ou autorités publiques se succéderont pour démontrer l’importance des microbiotes sur notre santé. Inaugurée pendant la campagne WAAW 2024, cette série de conférence est une occasion unique d'approfondir vos connaissances sur les microbiotes mais aussi de toucher du doigt des grandes causes de santé publique (antibiorésistance, maladies digestives, resistome, importance des 1000 premiers jours de vie, santé de la femme…)
Consultez le programme de la toute première MicrobiTalk !
- Comprendre les microbiotes
- Microbiote et troubles associés
- Agir sur nos microbiotes
- Publications
- À propos de l’Institut
Section professionnels de santé
Retrouvez ici votre espace dédié
en_sources_title
en_sources_text_start en_sources_text_end
Chapitres

A propos de cet article

Vanessa Carter
L'implication des patients et du grand public, essentiels pour lutter contre la RAM

« La résistance aux antibiotiques n'est pas suffisamment discutée avec les patients et nombre d'entre eux n'en comprennent pas les fondements. En enseignant aux gens le bon usage des antibiotiques, nous pouvons leur donner les moyens de faire partie de la solution.
Présidente du groupe de travail de l'OMS sur les survivants de la résistance aux antimicrobiens. Elle est devenue défenseuses des patients de la RAM en 2013 après avoir survécu à un grave accident de voiture et suite à une reconstruction faciale qui a duré 10 ans et qui a provoqué une infection à SARM hautement résistante contre laquelle elle s'est battue pendant 3 ans.
C'est donc ce que j'appelle mon... Ou quelle a été ma dernière photo prise à l'âge de 25 ans. Sur le côté droit, ma mère, la photo de nos trois générations, ma grand-mère et moi-même.
Très peu de temps après, j'ai eu un accident de voiture à Johannesburg, en Afrique du Sud. Une voiture nous a dépassés du mauvais côté de la route. Nous avons fait une vrille violente et nous avons heurté un mur de béton.
J'ai été réanimé sur place et j'ai été emmené à l'hôpital universitaire Charlotte Maxeke de Johannesburg, où j'ai été mis sous assistance respiratoire, et j'ai eu de multiples blessures à l'abdomen, au cou, au dos, et aussi à mon bassin, et beaucoup d'os cassés sur le côté droit de mon visage. et j'ai aussi perdu l'œil droit. Donc, une fois que j'ai été libéré, j'ai dû faire face à un voyage de neuf ans devant moi pour reconstruire mon visage, car c'était une zone très compliquée et très endommagée. Il s'agit donc essentiellement d'un instantané de ce à quoi ressemblait mon parcours. J'ai donc dû implanter beaucoup de prothèses.
Sur ma quatrième prothèse, qui devait être implantée environ six ans plus tard, après avoir reçu mon congé de l'opération, je suis allé faire des courses. J'ai baissé le rétroviseur et j'ai vu cette décharge sortir de mon visage. J'ai eu une telle peur que j'ai fini par appeler mon chirurgien plasticien et il m'a dit : « On dirait que ça pourrait être une infection. Nous devons faire une opération d'urgence », ce que nous avons fait. J'ai été libéré.
Deux semaines plus tard, l'infection était de retour. Ils ont fait une opération très similaire. Ils ont dû nettoyer la prothèse et faire de la chirurgie reconstructive. J'ai été libéré. Mais deux semaines plus tard, l'infection est revenue, semblant s'aggraver. J'ai ensuite été admise pour un drainage des sinus, car je n'étais pas seulement sous les soins d'un chirurgien plasticien, j'avais une équipe multidisciplinaire. J'ai dû aussi consulter le chirurgien ORL, le chirurgien maxillo-facial, le chirurgien plasticien, un ophtalmologiste. Chacun d'entre eux donnait des opinions différentes et prescrivait des antibiotiques entre les deux, je les voyais tous. Et bien sûr, comme je l'ai dit, j'ai eu ces chirurgies continues avec l'infection réapparaissant deux semaines à chaque fois. Finalement, il ne me restait presque plus de visage.
Onze mois après la première fois que j'ai vu cette infection, et que cette infection est revenue quatre fois, elle avait rongé beaucoup de tissus, et ils ont dû retirer la prothèse en urgence. Et mon chirurgien plasticien l'a envoyé pour des tests. C'était la première fois que j'entendais ce mot « tester ». Alors j'ai téléphoné aux bureaux de pathologie et j'ai dit : « S'il vous plaît, est-ce que je peux en voir une copie pour comprendre ce qui se passe ? » Et quand ils me l'ont envoyé, il y avait beaucoup de R, il y avait environ quatre ou cinq S, ce qui voulait dire que j'étais... Je suis sûr que la plupart d'entre vous travaillent en microbiologie, vous savez.
Cela signifiait que j'étais soit résistant, soit sensible aux différents antibiotiques qui se trouvaient sur le côté gauche. Et j'avais un SARM très résistant aux médicaments, une infection à Staphylococcus aureus résistant à la méthicilline. Mes médecins m'avaient maintenant abandonné, parce que c'était peut-être trop d'effets dommageables. De plus, j'avais aussi le problème de l'infection, étant un patient à haut risque, avec l'infection qui revenait.
J'ai pris mes antécédents médicaux. J'ai dû contacter environ 25 chirurgiens à l'étranger, car à Johannesburg, en Afrique du Sud, il y avait une pénurie du type de médecin dont j'avais besoin. J'ai contacté un médecin du Brigham and Women's Hospital de Boston, qui m'a passé un appel Skype de 30 minutes et m'a donné des instructions sur ce que je devais faire, c'est-à-dire couper l'os, éviter tout autre objet étranger. Nous ne pouvions pas faire de chirurgie plastique. Nous avons d'abord dû faire la chirurgie maxillo-faciale. Il m'a dit, maintenant suivez ce conseil et allez trouver un médecin à Johannesburg qui imite exactement ce que j'ai dit, ce que j'ai fait.
Après en avoir visité un certain nombre, j'ai trouvé un médecin. Vous pouvez le voir en bas à droite. Il s'appelait le professeur Reyneke, et il a effectué l'opération, et elle avait l'air incroyable. Nous n'arrivions pas à croire que nous nous étions débarrassés de ce déficit. J'avais l'impression que cela en valait la peine. Parce qu'il s'est écoulé essentiellement un an entre le moment où ils ont retiré la prothèse et le moment où nous avons pu la réparer.
Mais comme un mauvais cas de déjà-vu, l'infection est revenue. Cette fois, ce n'était pas seulement dans la peau, c'était aussi dans l'os. J'avais donc une ostéomyélite, et j'avais également développé une allergie à l'antibactérien topique qu'ils utilisaient sur la peau. À ce moment-là, vous pouvez imaginer que mon cœur s'est serré, j'ai complètement perdu espoir, parce que je ne battais pas cette infection résistante.
Mais le professeur Reyneke a essentiellement commencé à faire tourner les antibiotiques de dernier recours. Alors il me faisait prendre un pendant deux semaines, pendant 10 jours, je devais y retourner et il le vérifiait et il me mettait sur une voie différente en fonction de la façon dont je répondais à eux.
Et trois mois plus tard, après avoir fait cela, il a recommencé à s'éclaircir. Puis, probablement environ deux semaines plus tard, je me suis retrouvé à l'hôpital avec une occlusion intestinale adhésive. Mon estomac, je pense à cause de toute l'utilisation de ces antibiotiques,
J'ai fini par me faire enlever une partie de mes intestins. J'avais aussi des problèmes d'adhérences, mais bien sûr, les antibiotiques n'aidaient pas la situation. Après avoir traversé cela, c'est un peu le résultat.
Encore une fois, neuf ans, un peu moins de 10 ans à devoir lutter contre tout cela. Et bien sûr, trois années au total passées à lutter contre les infections résistantes. Lorsque nous avons terminé avec cela, et je n'ai pas mis toutes mes diapositives ici, mais l'une des choses qui m'a beaucoup frustré était que ce n'était pas de notoriété publique. Pourquoi la résistance aux antibiotiques n'était-elle pas discutée avec moi en tant que patient ?
J'ai beaucoup travaillé depuis. L'une des choses que j'ai faites plus récemment est de créer un organisme de bienfaisance appelé AMR Narrative, qui se concentre sur le développement des capacités de plaidoyer et la sensibilisation, principalement axé sur les patients et le public. Et bien sûr, nous travaillons dans les quatre secteurs différents, comme mes collègues viennent de le dire tout à l'heure, une perspective de santé.
C'est un exemple de l'un des programmes de formation que nous avons mis en place récemment à Bruxelles, en partenariat avec le Forum européen des patients. En fait, nous enseignons aux patients les bases de la résistance aux antibiotiques parce que ces conversations n'ont toujours pas lieu. Cette photo montre 30 jeunes défenseurs des droits des patients atteints de problèmes de santé à long terme qui souhaitent commencer à plaider en faveur de la résistance aux antimicrobiens dans leur propre région. Voici quelques instantanés, je reviens tout juste de... Je participe à beaucoup d'événements, mais il y en a quelques-uns ici qui ont été organisés à l'Assemblée générale des Nations Unies, dont je parlerai un peu lors de la table ronde dans une minute, où j'ai ouvert la réunion multipartite avec le Vice-président général des Nations Unies et le Président de l'Assemblée générale. Très, très importante, c'est cette déclaration politique sur laquelle ils viennent de travailler. J'y reviendrai dans une minute.
Voici quelques-uns des outils et ressources que nous avons fournis par l'organisme de bienfaisance. Si vous allez sur notre site Web, vous pourrez en voir un certain nombre. Nous avons également créé une vidéo pour les patients et le public afin d'en apprendre un peu plus sur le plan vulgarisé, car il s'agit d'un sujet très scientifique. Notre objectif principal est de le rendre compréhensible pour tout le monde. Et ce serait tout. C'est ainsi que vous pouvez nous joindre sur les réseaux sociaux.
Merci beaucoup.
3 messages clés
- Lutte contre une infection résistante : Vanessa Carter fait part de son expérience personnelle de lutte contre une infection à Staphylococcus Aureus résistant à la méthicilline (SARM), qui a nécessité de multiples interventions chirurgicales et traitements antibiotiques sur une période de neuf ans à la suite d'un accident de voiture.
- Importance de la sensibilisation à la résistance aux antibiotiques : Elle souligne le manque de communication et de sensibilisation des patients à la résistance aux antibiotiques (RAM), ce qui l'a incitée à créer une organisation caritative, l'AMR Narrative, pour éduquer et sensibiliser le public et les patients à cette question cruciale.
- Collaboration multidisciplinaire et internationale : Vanessa souligne l'importance de la collaboration entre divers spécialistes médicaux et de la recherche d'avis internationaux pour traiter son infection complexe, ce qui illustre la nécessité d'une approche globale et coordonnée dans la gestion des infections résistantes.
Téléchargez sa présentation (en anglais uniquement)

Pr. Etienne Ruppé
Le microbiote intestinal et la résistance aux antibiotiques

« Les professionnels de la santé doivent communiquer clairement sur la résistance aux antibiotiques aux patients, car des malentendus persistent. Nous devrions nous concentrer sur l'environnement au sens large plutôt que d'accuser le microbiote d'être à l'origine de la résistance ».
Ses recherches portent sur la résistance aux antibiotiques, sur les interactions entre le microbiote et l'émergence de bactéries résistantes, sur la dynamique des gènes de résistance aux antibiotiques (le résistome) et sur le diagnostic des infections, avec un accent particulier portée à l'application de nouveaux outils de séquençage.
Le microbiote intestinal et la résistance aux antibiotiques:
Merci beaucoup pour l'invitation et cette merveilleuse conférence que vous organisez aujourd'hui. Le titre de mon exposé est au cœur de ce que vous proposez aujourd'hui, le microbiote intestinal étant au cœur de la résistance aux antibiotiques.
Commençons par une représentation très simpliste du microbiote intestinal et des bactéries résistantes qu'il peut héberger. Vous savez, je pense, que le microbiote intestinal abrite un grand nombre de micro-organismes différents, le dominant étant les bactéries. Nous avons des centaines d'espèces que nous estimons, et la plupart d'entre elles sont des bactéries commensales, strictement anaérobies, que nous cultivons avec beaucoup de difficulté en laboratoire, et la plupart d'entre elles que nous ne cultivons pas du tout. Ensuite, nous avons eu les agents pathogènes opportunistes tels que les entérobactéries, les entérocoques, et ils sont sous-dominants dans le microbiote intestinal en raison de ce que nous appelons l'effet de barrière ou la résistance à la colonisation. Cette pression exercée par les bactéries anaérobies sur cet agent pathogène opportuniste, a une propriété très importante, et nous verrons que lorsque nous prenons des antibiotiques, nous perturbons simplement cet équilibre.
Lorsque nous sommes porteurs des bactéries résistantes dont nous allons parler aujourd'hui, elles sont même sous-dominantes dans leur population d'agents pathogènes opportunistes. Nous sommes ici aujourd'hui parce que la résistance aux antibiotiques est un problème majeur, et nous savons maintenant depuis quelques années qu'elle tue beaucoup de gens dans le monde. Nous estimons le nombre de décès à environ un million par an. Si nous ne faisons rien, si nous ne réagissons pas, il pourrait y avoir un total d'environ 40 millions de morts au cours des 30 prochaines années.
Vous voyez ici sur ce graphique les principaux tueurs. Ce que je veux souligner ici, c'est que la plupart d'entre eux sont des entérobactéries, acinetobacter baumannii, pseudomonas aeruginosa, la moitié d'entre eux. Je pense que la majeure partie du problème de la résistance aux antibiotiques réside dans ces bactéries de nos jours.
Ensuite, vous pouvez également voir les petits cercles avec les couleurs. Ce sont les agents pathogènes pour lesquels l'OMS dit qu'il existe un besoin critique élevé ou moyen de nouveaux antibiotiques.
Ensuite, nous avons ces petits emojis de caca ici, et ils indiquent qu'avant de provoquer des infections, ces bactéries se trouvent dans l'intestin. Ils vont coloniser le microbiote intestinal avant de provoquer des infections. C'est pourquoi le microbiote intestinal est vraiment au cœur de la résistance aux antibiotiques.
Si nous parvenons à contrôler, à comprendre ce qui se passe dans le microbiote intestinal, alors nous avons un levier pour lutter contre les bactéries résistantes. Bien sûr, c'est un bel équilibre, cet effet barrière à la résistance à la colonisation.
Mais que se passe-t-il si nous prenons des antibiotiques ?
Puis on rompt cet équilibre, on passe d'un microbiote riche et diversifié à quelque chose de moins diversifié, de moins riche. Bien sûr, tous les antibiotiques n'exercent pas le même effet sur le microbiote. Cela dépend de la quantité qu'ils sont excrétés dans l'intestin, de l'étendue de leur spectre. Et en fonction de ces variables, il y a alors une perturbation du microbiote.
Si vous êtes déjà porteur de bactéries résistantes, elles vont se dilater. Ils favorisent également l'implantation et la colonisation de nouvelles bactéries résistantes. Et cela a des conséquences.
Encore une fois, ce qui se passe dans votre intestin a des conséquences externes. Et nous et d'autres avons montré que plus vous portez de bactéries résistantes dans l'intestin, plus vous serez à risque d'infections causées par ces bactéries résistantes telles que les infections des voies urinaires, la translocation bactérienne, en particulier chez les patients neutropéniques.
Vous vous répandrez davantage dans l'environnement, et c'est important. Si vous êtes dans une structure de soins, cela favorisera les transmissions croisées vers d'autres patients. Vous le porterez plus longtemps, il est même lié à la pneumonie. Il existe un lien entre l'intestin et la pneumonie chez les patients en soins intensifs, où la pneumonie finit par être colonisée dans la gorge par des bactéries résistantes de votre intestin.
Ces commensaux que nous avions avec les bactéries anaérobies, ne sont pas dépourvus de gènes de résistance aux antibiotiques (ARG). Ils sont simplement différents des gènes résistants portés par les agents pathogènes.
Ainsi, il y a quelques années, lorsque j'étais à l'IAME, près de Paris, nous avons caractérisé cette résistance humaine à partir des tripes. Et vous verrez qu'il est très diversifié avec plus de 6 000 gènes résistants. Nous, tous dans cette pièce, portons en moyenne 1000 gènes résistants dans notre intestin. Ils ont une très faible identité avec les gènes résistants que nous connaissons des agents pathogènes. Ils sont principalement chromosomiques. Et avec tout ça, tous ces arguments, on commençait à penser qu'ils n'étaient peut-être pas si mauvais, parce qu'il est vraiment difficile pour eux d'être transférés à des agents pathogènes. Et je veux dire, nous voulons que nos bactéries commensales soient résistantes aux antibiotiques. Alors peut-être que la résistance aux antibiotiques n'est pas si mauvaise selon le type de bactéries qu'elles sont.
C'était ma courte présentation introduisant quelques sujets pour aujourd'hui. Ce que je voulais souligner, c'est que le microbiote intestinal est principalement constitué de bactéries anaérobies où les pathogènes opportunistes sont sous-dominants. La majorité des bactéries qui causent le plus gros problème en termes de résistance aux antibiotiques ont un réservoir intestinal avant de provoquer des infections. Lorsque nous prenons des antibiotiques, nous favorisons l'expansion de cette bactérie dans l'intestin, ce qui entraîne des conséquences cliniques. Nous n'oublierons pas nos bonnes bactéries, nos bonnes commensaux. Ils ont beaucoup de gènes résistants, et ils ne sont pas largement transférés aux agents pathogènes bactériens.
Sur ce, merci beaucoup.
3 messages clés
- Rôle du microbiote intestinal dans la résistance aux antibiotiques : Le microbiote intestinal, qui comprend une vaste gamme de micro-organismes, joue un rôle crucial en hébergeant à la fois des bactéries commensales et des bactéries pathogènes opportunistes. L'équilibre au sein de ce microbiote est essentiel pour prévenir la prolifération de bactéries résistantes.
- Impact des antibiotiques sur le microbiote et la résistance : L'utilisation d'antibiotiques perturbe l'équilibre du microbiote intestinal, réduisant sa diversité et permettant aux bactéries résistantes de se développer. Cette perturbation peut entraîner un risque accru d'infections, de propagation dans l'environnement et de transmission croisée dans les établissements de soins de santé.
- Importance de comprendre et de préserver les bactéries commensales : Si les bactéries commensales de l'intestin sont porteuses de nombreux gènes de résistance aux antibiotiques, ces gènes ne sont pas facilement transférés aux agents pathogènes. Il est vital de maintenir une population saine de ces bactéries commensales, car elles jouent un rôle protecteur et leur résistance n'est généralement pas nocive.
Téléchargez sa présentation (en anglais)

Pr. Søren Johannes Sørensen
Résistance aux antibiotiques et microbiote intestinal du nourrisson
« Les enfants traités fréquemment avec des antibiotiques dès leur plus jeune âge sont porteurs d'un plus grand nombre de gènes résistants aux antibiotiques, en particulier E. coli, dont la résistance est influencée par les antibiotiques pris par leur mère, ce qui affecte leur santé à long terme. »
Lier le résistome au début de la vie et la maturation du microbiote.
Ses recherches se concentrent sur les interactions dans les populations microbiennes et évaluent l'étendue du flux génétique au sein des communautés naturelles et leur réponse aux perturbations environnementales.
Résistance aux antibiotiques et microbiote intestinal du nourrisson:
Je vous remercie beaucoup de cette présentation et de m'avoir donné l'occasion de m'adresser à vous aujourd'hui.
Je pense que nous reprenons, en fait, nos recherches suivent tout à fait ce que nous venons d'entendre, parce que nous avons étudié une cohorte d'enfants danois.
En fait, ce n'est pas tant le début de cette recherche pour comprendre la résistance aux antibiotiques, mais nous voulions comprendre comment le microbiote tôt dans la vie façonne la santé plus tard, et plus particulièrement dans ce cas-ci, en examinant l'asthme, les allergies et ces types de maladies.
Nous étudiions déjà le microbiote au début de la vie, puis nous avons vu des résultats apparaître, qu'une grande partie de la résistance aux antibiotiques se trouve en fait dans un réservoir du microbiote intestinal des adultes.
Nous étions curieux de nous demander à quel moment cela allait être établi.
Est-ce quelque chose que nous acquérons tard dans la vie ?
Ou si nous regardions déjà ces enfants ?
En fait, nous suivions ces enfants depuis leur naissance. Les données que nous examinions dataient de l'époque où les enfants avaient 1 an, et c'est ce que je vais présenter.
La question que nous nous posions était la suivante : y a-t-il déjà des enfants danois résistants aux antibiotiques à l'âge d'un an ? Et la réponse triste et courte est oui.
Il y en a déjà beaucoup à ce moment-là. Ce que nous avons trouvé, ce qui nous a surpris, c'est qu'en bas du graphique, vous voyez la répartition des enfants et le nombre de gènes de résistance aux antibiotiques qu'ils ont. Ainsi, certains enfants n'ont pas beaucoup de gènes de résistance aux antibiotiques, alors qu'en réalité, une autre population d'enfants en a beaucoup. Et non seulement ils avaient de nombreux types différents de gènes de résistance aux antibiotiques, mais ils les avaient également en plus grande abondance.
Les enfants ont été divisés en deux groupes. Par conséquent, nous étions curieux d'essayer de comprendre ce qui détermine vraiment chez l'enfant si tôt, s'il avait beaucoup ou pas tant de résistance aux antibiotiques. Comme nous avons suivi cette cohorte très, très attentivement avec beaucoup de données, nous pourrions en fait essayer d'examiner certaines de ces choses.
Le cercle autour de ce cercle est en quelque sorte toutes ces métadonnées que nous avons, et l'une d'entre elles peut en être la cause. Ce que nous trouvons moins surprenant, c'est que si les enfants ont été abonnés à des antibiotiques pour le traitement, assez souvent au début de la vie, pour traiter les maladies des voies respiratoires par exemple, alors ils avaient un risque beaucoup plus élevé d'être dans le groupe d'enfants qui avaient beaucoup de résistance aux antibiotiques. Il y avait un lien très clair là-bas. Ce que nous avons également découvert, c'est que si les mères pendant la grossesse, ces enfants ont maintenant un an, si elles prenaient des antibiotiques, alors l'enfant, un an plus tard, était beaucoup plus susceptible d'avoir beaucoup de résistance aux antibiotiques par rapport à moins.
Même les mères qui prennent des antibiotiques pendant la grossesse semblent être très importantes pour cela. Nous avons également trouvé d'autres corrélations qui sont peut-être moins évidentes. Les personnes vivant dans une zone urbaine ont plus de risques d'avoir une résistance aux antibiotiques que les personnes vivant dans une zone rurale.
Si vous avez un animal de compagnie dans votre maison, vous avez moins de risque d'avoir une résistance aux antibiotiques, il y a donc de nombreux facteurs. Cela devient de plus en plus compliqué, mais nous avons vu une chose très claire, pas si surprenante.
Si vous prenez des antibiotiques, votre enfant a un risque beaucoup plus élevé. En fait, nous voyons beaucoup d'antibiotiques être prescrits aux enfants. Cependant, si vous regardez ensuite du côté droit, vous voyez un diagramme montrant à quels antibiotiques ils sont résistants. Les rouges sont les antibiotiques réellement prescrits à la mère ou à l'enfant. Mais nous voyons les deux dominants, ceux contre lesquels nous trouvons le plus de résistance, ils n'ont jamais été prescrits, ni à l'enfant, ni à la mère.
C'est pour montrer que ces choses sont moins simples à comprendre que ce que nous voyons assez souvent.
Nous avons donc essayé d'enquêter davantage. Nous avons pensé qu'une explication à cela pourrait être que nous avons une co-sélection. Ce que nous savons souvent, c'est que la résistance aux antibiotiques n'est pas la seule. C'est en fait dans le génome avec d'autres résistances aux antibiotiques.
Nous avons commencé à chercher à savoir s'il y avait une cosélection. C'est ce que montre ce graphique. C'est probablement très difficile pour vous de le voir ici, mais ce que nous avons découvert très clairement, c'est que les deux gènes de résistance aux antibiotiques très abondants sont co-localisés avec la résistance aux antibiotiques avec laquelle ils sont traités. Ce que nous voyons ici, c'est que lorsque nous donnons un antibiotique, et peu importe lequel, cela provoque la réunion de tout un ensemble de gènes de résistance aux antibiotiques.
Lorsque nous avons examiné de plus près la cosélection ici pour voir non seulement quels résistants aux antibiotiques étaient trouvés ensemble, mais aussi pourquoi ils étaient également associés à d'autres gènes, nous avons constaté qu'ils étaient assez souvent avec des gènes virulents. En fait, lorsque vous sélectionnez la résistance aux antibiotiques avec des antibiotiques, non seulement les bactéries deviennent résistantes aux antibiotiques, mais elles deviennent également un agent pathogène plus grave. En fait, ils acquièrent en même temps des gènes qui en font un agent pathogène plus persistant et plus virulent. Enfin, ce que nous avons vu, c'est qu'ils étaient également co-localisés avec des gènes mobiles.
Ce que les bactéries peuvent faire, ce qui est fantastique quand on y pense, c'est qu'elles peuvent échanger des gènes entre elles. Si une bactérie rencontre une autre bactérie et dit : « Oh, j'aime la couleur de vos yeux », alors elle peut la changer, et elle a alors la même couleur.
Bien sûr, ils n'ont pas d'yeux, mais ils ont des gènes de résistance aux antibiotiques, de sorte qu'ils peuvent échanger un trait d'une bactérie à une autre. Et il s'agit souvent d'un élément génétique mobile. Et ce que nous avons montré très clairement ici, c'est que la résistance aux antibiotiques est assise chez ces enfants ensemble dans de gros paquets sur des éléments génétiques mobiles afin qu'ils puissent l'échanger dans l'intestin entre une bactérie ou une autre.
Donc, même s'il ne s'agit peut-être pas d'une bactérie potentiellement pathogène dans l'intestin des enfants, peut-être que s'ils attrapent des bactéries pathogènes, ils peuvent les acquérir là-bas. Mais ce n'est pas tout, je veux dire que lorsque nous pensons à la probabilité, et s'il s'agit d'une bactérie des voies respiratoires, peut-être qu'elle ne pénètre jamais dans l'intestin. Le fait est, cependant, qu'une bactérie intestinale n'est pas toujours dans l'intestin.
Nous tous, y compris les enfants, allons aux toilettes plusieurs fois par jour. Ainsi, les bactéries intestinales quittent en fait l'intestin. Ils sont jetés dans les toilettes. Et c'est en fait un phénomène important sur lequel nous devons également enquêter
3 messages clés
-
Établissement précoce de la résistance aux antibiotiques chez les enfants : Des recherches menées sur des enfants danois montrent que la résistance aux antibiotiques peut s'installer dès l'âge d'un an. Les enfants exposés aux antibiotiques tôt dans leur vie, ou dont les mères ont pris des antibiotiques pendant la grossesse, sont plus susceptibles d'être porteurs d'un nombre élevé de gènes de résistance aux antibiotiques.
-
Facteurs influençant la résistance aux antibiotiques : Différents facteurs influencent la présence de la résistance aux antibiotiques chez les enfants, notamment la vie urbaine, l'utilisation d'antibiotiques et même la présence d'animaux domestiques. L'étude a révélé que les enfants vivant dans les zones urbaines présentaient une résistance plus élevée, tandis que ceux qui vivaient à la campagne ou qui avaient des animaux de compagnie présentaient une résistance plus faible.
-
Co-sélection et échange de gènes entre bactéries : Les gènes de résistance aux antibiotiques sont souvent situés avec d'autres gènes de résistance et de virulence sur des éléments génétiques mobiles. Cela permet aux bactéries d'échanger ces gènes, ce qui augmente le risque de propagation de la résistance et rend les agents pathogènes plus virulents.
Téléchargez sa présentation (en anglais)
Antibiotiques : quels impacts sur le microbiote et notre santé ?

Elitsa Penkova
La résistance aux antimicrobiens dans les rivières - un risque pour la santé publique ?

« Les antibiotiques que nous prenons finissent dans les déchets, polluant les rivières avec des bactéries résistantes, affectant la santé publique, comme les nageurs sauvages. »
Elitsa Penkova est doctorante à l'université d'Exeter et se consacre à l'évaluation des risques sanitaires liés à l'exposition à la résistance aux antimicrobiens (RAM) dans les environnements d'eau douce. Ses recherches portent en particulier sur la manière dont les nageurs des rivières peuvent être exposés à des bactéries et des gènes résistants aux antibiotiques, afin de comprendre les implications potentielles pour la santé publique de la transmission de la résistance aux antimicrobiens dans les environnements naturels d'eau douce.
La résistance aux antimicrobiens dans les rivières - un risque pour la santé publique ?:
Merci pour l'introduction et merci de m'avoir invitée. Maintenant, vous vous demandez peut-être quel est le rapport entre la résistance aux antimicrobiens et les rivières. C'est un problème hospitalier, n'est-ce pas ? Mais pour des gens comme moi qui étudient la résistance aux antibiotiques, ces environnements sont particulièrement intéressants parce qu'ils contiennent déjà, tous les composants nécessaires, à l'évolution de la résistance, pour se rassembler en un seul endroit, comme certains de nos intervenants y ont déjà fait allusion.
Donc, tout d'abord, dans les rivières, nous avons des bactéries environnementales, et la majorité d'entre elles ne sont pas considérées comme nocives pour la santé publique. Certains peuvent l'être, bien sûr, mais la majorité sont impliqués dans des choses comme le cycle des nutriments, et ils ne sont qu'une partie normale de l'écosystème environnemental.
Mais la raison pour laquelle ils sont si intéressants est qu'ils portent divers mécanismes de résistance. En effet, pendant un millénaire, ils ont eu le temps de coexister avec divers types de micro-organismes qui produisent des molécules antibiotiques. Et les microbes produisent ces molécules pour communiquer entre eux ou pour se combattre les uns les autres. Pour pouvoir coexister aux côtés de ces microbes producteurs de molécules antibiotiques, les bactéries environnementales ont dû s'adapter et faire évoluer diverses stratégies d'adaptation ou mécanismes de résistance.
Le vrai problème ici est lorsque ces mécanismes de résistance deviennent transférables, car contrairement aux humains qui ne peuvent transmettre des gènes que d'un parent à notre progéniture, les bactéries peuvent en fait partager des gènes entre des espèces apparentées et non apparentées.
Bien qu'il soit vraiment fascinant de voir comment ils peuvent littéralement partager un gène d'une cellule à l'autre dans l'exposé précédent, c'est aussi vraiment terrifiant car cela signifie qu'une fois qu'un mécanisme de résistance a émergé et est devenu transférable, il a le potentiel de se propager très rapidement au sein et entre les populations bactériennes.
Et c'est aussi ainsi que les bactéries sont capables d'accumuler plusieurs gènes résistants en même temps, c'est ainsi que nous passons d'une bactérie résistante à ce que nous appelons une superbactérie. Et ici, j'ai inclus un exemple de la capacité à partager des gènes entre les bactéries environnementales et les agents pathogènes cliniquement importants.
L'exemple ici est celui des bêta-lactamines. Désolé, résistance aux bêta-lactamines. Les bêta-lactamines sont une classe d'antibiotiques qui sont le plus souvent utilisés dans le monde entier dans le mécanisme de résistance, que les bactéries utilisent pour surmonter la toxicité de ces antibiotiques, c'est-à-dire la résistance aux bêta-lactamines. La résistance aux bêta-lactamines sont des enzymes qui se lient à l'antibiotique et le dégradent, essentiellement. Mais on considère que les gènes qui codent pour ces enzymes ont évolué à l'origine dans les bactéries environnementales et ne sont transférés que plus tard à des agents pathogènes cliniquement importants.
Et c'est juste pour illustrer que même si les bactéries environnementales ne constituent pas nécessairement une menace pour la santé publique, elles peuvent servir de réservoir pour des agents pathogènes cliniquement importants, qui, soit dit en passant, se trouvent également dans les rivières. Ainsi, avec nos déchets, nous enrichissons continuellement les rivières d'autres environnements naturels d'eau douce avec des bactéries associées à l'homme et à l'animal, mais aussi avec divers composés antimicrobiens, y compris des antibiotiques, bien sûr.
Lorsque nous prenons des antibiotiques, nous ne les métabolisons pas complètement, et la majorité d'entre eux peuvent être excrétés directement dans nos toilettes, puis évacués dans nos systèmes de traitement des eaux usées. Il existe différentes façons de traiter les déchets, mais aucune d'entre elles n'est conçue spécifiquement pour éliminer les gènes de résistance aux antibiotiques ou les composés antimicrobiens. Certains d'entre eux finiront donc par se retrouver dans les rivières.
Et en plus de cela, bien sûr, nous entendons de plus en plus souvent dire que les plans de traitement des eaux usées sont autorisés à rejeter les eaux usées non traitées ou partiellement traitées directement dans les rivières lors de fortes pluies. Il s'agit d'éviter qu'ils ne soient submergés et d'empêcher les eaux usées de refouler les maisons des gens, ce qui est assez juste. Mais nous ne savons pas vraiment ce que cela signifie pour la communauté croissante de nageurs sauvages, ce sur quoi se concentrent mes recherches.
Et en fait, on se concentre très peu sur la façon dont l'exposition à la résistance aux antimicrobiens dans ces environnements affecte la santé publique.
Nous savons, grâce à des travaux antérieurs en Norvège, à une étude cas-témoins, que la natation en eau douce a été identifiée comme un facteur de risque indépendant de contracter des infections résistantes, des infections urinaires résistantes.
Nous savons également, grâce à une étude menée en Norvège, que la natation en eau douce représentait environ 6 % de l'acquisition de cas résistants dans la communauté pendant les mois d'été.
Nous le savons, grâce à une étude sur les nageurs côtiers du Royaume-Uni, donc pas les nageurs d'eau douce, mais les nageurs côtiers. Les surfeurs sont quatre fois plus susceptibles d'être porteurs de bactéries résistantes aux antibiotiques que les personnes qui ne vont pas dans l'eau.
Et à l'instar de cette étude, je cherche maintenant à comprendre si les nageurs en eau douce courent un risque élevé de porter des bactéries résistantes dans leurs intestins. Mais comme je suis toujours en train de collecter mes échantillons, je ne suis pas encore en mesure de parler de mes découvertes, mais je serai heureux de répondre à vos questions si vous en avez.
Merci
3 messages clés
-
Les rivières, réservoirs de résistance aux antibiotiques : Les rivières contiennent des bactéries environnementales qui ont développé divers mécanismes de résistance au cours des millénaires. Ces bactéries peuvent transférer des gènes de résistance à des agents pathogènes cliniquement importants, ce qui fait des rivières d'importants réservoirs de résistance aux antibiotiques.
-
Impact des eaux usées sur le microbiote des rivières : les déchets humains et animaux, ainsi que les composés antimicrobiens, sont continuellement déversés dans les rivières via les eaux usées. Les stations d'épuration ne sont pas conçues pour éliminer les gènes de résistance aux antibiotiques, ce qui entraîne l'enrichissement des rivières avec ces gènes, en particulier lors de fortes pluies, lorsque des eaux usées non traitées sont déversées.
-
Risques pour la santé publique des nageurs en eau douce : L'exposition aux bactéries résistantes aux antibiotiques dans les rivières constitue un risque pour la santé publique, en particulier pour les nageurs en eau douce. Des études ont montré que la natation en eau douce peut augmenter le risque de contracter des infections résistantes, soulignant la nécessité de poursuivre les recherches sur l'impact de la résistance aux antimicrobiens dans les milieux aquatiques naturels.
Téléchargez sa présentation (en anglais)

Edith Odeh
Ampiclox et contraception, sensibilisation à la lutte contre la résistance aux antimicrobiens

« La sensibilisation à la santé reproductive est essentielle dans les communautés où de nombreuses femmes sont mal informées. La connaissance renforce l'autonomie et améliore la société."
Pharmacienne passionnée et engagée au Nigeria, Edith est la fondatrice de Kings Heritage Pharmaceutical Limited, Asaba, Nigeria.
Elle a ouvert un centre de santé réunissant pharmaciens, médecins et bénévoles pour fournir des informations fiables sur les méthodes contraceptives et alerter les femmes sur les conséquences à long terme de l'abus d'antibiotiques, comme la dysbiose du microbiote et la résistance aux antimicrobiens.
Cette ambition lui a valu le premier prix Henri Boulard en 2021.
Je veux commencer par partager mes premières inspirations et motivations. En 2015, au début de ma carrière de pharmacien d'officine, un jour fatidique, un père a amené son enfant de 13 ans qui souffrait d'une diarrhée sévère.
Donc, après un examen approfondi des antécédents médicaux du patient, j'ai décidé de commencer un traitement avec des probiotiques. Moins d'une heure après avoir commencé ce traitement, l'adolescent qui était arrivé avec un seau à déchets a pu quitter la pharmacie confortablement, vêtu uniquement de sa couche. Cette merveilleuse expérience a suscité mon intérêt pour l'engagement de Biocodex en faveur de la médecine fondée sur des preuves, m'inspirant à développer un projet de subvention intitulé Establishing One Health Facility pour aborder les méthodes de contraception sûres et dissiper les mythes entourant l'utilisation de la capsule Ampiclox comme contraceptif féminin au Nigeria.
Et vous vous demandez peut-être quelle est la corrélation entre Saccharomyces et la contraception ? Ayant fait preuve d'un tel niveau d'honnêteté et de standard, j'étais convaincu que cet institut avait un objectif sincère, et que si je méritais ce prix, j'allais gagner.
Venons-en maintenant à la portée de mon projet et à sa mise en œuvre. Le projet, qui s'est principalement concentré sur la santé reproductive et les méthodes de contraception sûres, a touché sept communautés, impliquant en moyenne 20 % de la population de chaque communauté. Nous avons distribué gratuitement du matériel éducatif sur la contraception, des anthelminthiques et des livres inspirants, afin de fournir à ces communautés des connaissances précises sur la reproduction et l'utilisation rationnelle des antibiotiques. Aujourd'hui, reconnaissant la sensibilité culturelle du projet, nous avons collaboré étroitement avec les chefs de communauté, les chefs religieux et les professionnels de la santé pour mettre à l'essai notre approche.
Cela a conduit à un taux de participation impressionnant de 20 % dans toutes les communautés. Grâce à ce projet, nous avons réussi à réduire le nombre de grossesses non désirées, à améliorer l'utilisation responsable des antibiotiques et à promouvoir les pratiques communautaires en matière de soins de santé, en nous appuyant sur des partenariats locaux. Nous avons réussi à céder, à obtenir le résultat du projet et à répondre à un besoin spécifique de la communauté. Dans une communauté où environ 50 % de la population féminine est mal informée et naïve quant à sa santé reproductive, c'était un énorme fardeau.
Mais grâce à ce projet, nous avons pu les sensibiliser, et ils sont maintenant mieux équipés avec des connaissances en matière de reproduction. Ils ont un meilleur contrôle. Voici donc quelques-unes des images de la sensibilisation.
King's Heritage Pharma Limited prévoit de former des représentants locaux dans chaque communauté qui serviront d'éducateurs et de champions continus de la santé reproductive. Nous visons également à étendre notre portée à d'autres communautés et à établir un partenariat plus solide avec les professionnels de la santé. Nous avons également l'intention d'améliorer l'initiative en collaborant davantage avec des influenceurs locaux.
Notre établissement de santé reproductive, qui est stratégiquement situé à Agbaroto-Otor, Ughelli, dans le nord de l'État du Delta, servira de centre de soutien et d'éducation. Aujourd'hui, alors que nous continuons d'étendre notre portée et d'établir des partenariats avec les professionnels de la santé pour un impact durable, nous invitons tous les professionnels de la santé, les dirigeants communautaires et les éducateurs à se joindre à nous pour faire progresser la santé reproductive et l'utilisation rationnelle des antibiotiques.
Grâce à votre soutien et à votre collaboration, nous pouvons donner plus de moyens à d'autres défenseurs, dissiper les mythes néfastes et fournir des ressources qui changent la vie. Ensemble, nous pouvons créer une communauté plus saine, informée et plus résiliente.
Merci.
3 messages clés:
-
Son inspiration et engagement en faveur de la médecine factuelle : C'est l'une des premières expériences d'Edith en tant que pharmacienne communautaire, le traitement d'un enfant souffrant de diarrhée sévère à l'aide de probiotiques, qui lui a inspiré son engagement en faveur de la médecine factuelle et l'a amenée à élaborer un projet de subvention axé sur la santé reproductive et les méthodes de contraception sûres au Nigéria.
-
Sensibilisation et éducation des communautés : Le projet a concerné sept communautés de son pays, impliquant 20 % de la population dans chacune d'entre elles, et a permis la fourniture de matériel éducatif sur la contraception et les antibiotiques. En collaborant avec les dirigeants communautaires et les professionnels de la santé, le projet a permis de réduire le nombre de grossesses non désirées et d'améliorer l'utilisation responsable des antibiotiques.
-
Impact durable et projets futurs : Le centre de santé reproductive de l'État du Delta du Nord, construit grâce à la subvention reçue, servira de centre de soutien et d'éducation, visant à établir des partenariats plus solides et à donner aux communautés les moyens d'acquérir des connaissances précises en matière de santé reproductive.
Téléchargez sa présentation (en anglais)

Greatman Adiela Owhor
Le projet des "100 stewards contre la RAM"

« Ce projet vise à responsabiliser les professionnels et les soignants et à mettre en œuvre des initiatives solides de gestion des antibiotiques dans les établissements de santé."
Greatman Adiela Owhor est un pharmacien dévoué et un créateur de contenu dans le domaine de la santé qui possède une solide expérience en matière de recherche, de gestion de projet et de promotion de la santé. Il est un chercheur émergent avec une expertise croissante, ayant déjà publié dans des revues respectées telles que *The Lancet* et *International Journal of Health Planning and Management. * Son travail a fait l'objet de plus de 150 citations et son indice H est de 3, ce qui témoigne de son impact dans le domaine.
L'engagement de M. Greatman en faveur de la santé publique a été largement reconnu. En 2021, il a reçu le prestigieux Diana Award du Royaume-Uni, une distinction décernée aux jeunes gens qui apportent une contribution significative à leur communauté. En outre, il a été nommé « Pharmacien de l'année » dans l'État de Rivers en 2020 et « Promoteur de la santé publique de l'année » en 2021. Son travail a été célébré par un reportage lors de la Journée mondiale du bénévolat au Nigéria (2020) pour sa contribution à la santé publique.
En 2023, M. Greatman a fondé *CommCase*, une plateforme innovante reliant les pharmaciens communautaires du monde entier pour traiter les cas difficiles rencontrés dans la pratique. CommCase a facilité la résolution de plus de 1 000 cas au cours de sa première année d'existence, ce qui lui a valu une large reconnaissance dans toute l'Afrique. Pour son travail avec CommCase, Greatman a été nommé « Top Pharmacy Innovator of 2023 » au Nigéria par Mega We Care Pharmaceuticals.
Les efforts de Greatman pour lutter contre la résistance aux antimicrobiens (RAM) ont atteint de nouveaux sommets en 2023 lorsqu'il a reçu le prix Henri Boulard de la santé publique. Grâce à ce prix, il a lancé une campagne nationale de sensibilisation à la résistance aux antimicrobiens qui a mobilisé des milliers de personnes en ligne et hors ligne et a permis d'accroître de 50 % la sensibilisation dans les zones ciblées.
Avec plus de 70 000 adeptes sur X (anciennement Twitter), M. Greatman continue de défendre la santé publique et la gestion de la résistance aux antimicrobiens. Pour l'avenir, il souhaite tirer parti de la promotion de la santé et de la technologie pour avoir un impact significatif sur la santé et le bien-être des communautés.
Je m'appelle Greatman Adiela et je suis le chef d'équipe du projet des "100 stewards contre l'AMR". Ce projet a été principalement conçu pour donner à 100 personnes les moyens de mener à bien des projets locaux de lutte contre la résistance aux antimicrobiens dans leur région.
Ce projet a été rendu possible grâce au soutien de la Fondation Biocodex.
Nous avons donc lancé une campagne en ligne de quatre mois au cours de laquelle nous avons contacté plus de 600 000 Nigérians et les avons interrogés sur les problèmes liés à la résistance aux antimicrobiens dans leur région.
Nous avons tiré parti de plateformes telles que Facebook, TikTok, Instagram, X et LinkedIn pour mener à bien cet engagement.
Rapidement suivi d'un repérage d'intendants, 100 d'entre eux, de leur formation, de leur compréhension de la résistance aux antimicrobiens et des enjeux propres à leur environnement, mais aussi d'un soutien dans la réalisation d'un projet local.
Le Nigeria est divisé en six zones géopolitiques, nous veillons donc à ce que nos 100 intendants soient répartis dans ces zones.
Nous nous sommes émus au bout de deux mois parce que les commissaires ont dépassé les attentes du projet. Nous sommes heureux d'avoir réalisé des projets dans des abattoirs, des marchés, des écoles et même dans la rue!
Nous avons veillé à ce que ces projets soient mesurables. Par conséquent, les délégués syndicaux ont dû procéder à une certaine forme d'évaluation pour obtenir des chiffres ou des chiffres sur la compréhension de la RAM dans leur région ou sur les questions liées à la RAM.
Puis, après leurs campagnes ou leurs projets, ils ont également été amenés à réévaluer les mêmes paramètres que ceux précédemment évalués pour voir s'il y avait eu une amélioration. Et nous nous en réjouissons, car certaines régions ont connu une augmentation de plus de 70 % de leurs connaissances sur la résistance aux antimicrobiens.
Nous sommes ravis de ce que nous avons fait au cours des derniers mois, et nous sommes encore plus enthousiastes à l'idée d'en faire plus à l'avenir.
Au nom de tous les intendants et de mon équipe, je tiens à remercier la Biocodex Microbiota Fondation d'avoir partiellement soutenu ce projet et d'avoir donné vie à tous nos rêves.
Merci!
3 messages clés
-
Formation des "stewards" contre la résistance aux antimicrobiens : Le projet des "100 stewards contre la RAM (Résistance Aux Antimicrobiens)"visait à donner à 100 personnes dans les six zones géopolitiques du Nigeria les moyens de mener à bien des projets locaux sur la résistance aux antimicrobiens. Ces responsables ont été formés pour comprendre les problèmes de résistance aux antimicrobiens propres à leur région et ont été aidés à mettre en œuvre des projets locaux mesurables.
-
Un vaste engagement en ligne : Le projet a débuté par une campagne en ligne de quatre mois qui a touché plus de 600 000 Nigérians par le biais de plateformes telles que Facebook, TikTok, Instagram, X et LinkedIn. Cette campagne a permis de sensibiliser le public à la RAM et de l'engager sur des questions connexes.
-
Impact significatif et projets futurs : Les projets des stewards ont conduit à une augmentation de plus de 70 % des connaissances sur la RAM dans certaines régions. Le succès de ces initiatives a motivé l'équipe à poursuivre ses efforts, en prévoyant de former davantage de représentants locaux et d'établir des partenariats plus solides pour un impact durable.
BMI-24.60